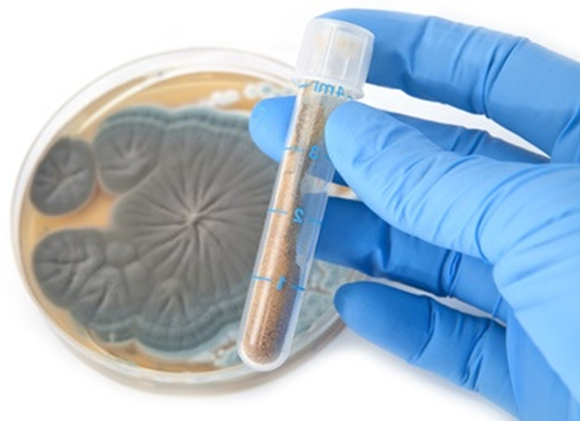
ペニシリン

なぜなら
薬は、つらい症状を緩和し、病気の進行を一時的に止めてくれるから。
薬ほど即効性のあるものはありません。緊急時にも頼れるものです。

ほとんどの薬は、病気の症状が起こる経路の一部を阻害することにより、その症状を起こさせないようにする「阻害剤」というのがより的確な表現です。
薬で一時的に楽になっている間に、身体が病気を治すのを待ちます。

しかし
大きな病気ではあっても、特にどこも痛くも無く、普段通りの生活が送れる場合があります。特に現代人の三大疾病がこれにあたります。
なぜなら、薬は、病気そのものを治してはくれないから。
医師が、つらい薬を飲まない最大の理由です。治してくれないのに、つらい思いはしたくないのです。
薬は人類の発明した素晴らしいものですが、人工的に合成された化学物質です。

市販薬でも副作用があります。
厚生労働省の調べでは、平成19年から平成23年度の5年間に報告された市販薬の副作用報告数は合計1220例で、毎年250症例前後報告されています。
本来、人間の身体に入れるべきものではなく、毒とも言えるもの。
それでも、病気のつらい症状を止めたり、病気の進行を一時的にでも止めてくれるから使用するものです。

薬は、リスクを知りながらも、一時的に、応急的に使用するものです。
薬は、病気を治すために使うものではなく、一時的に身体を楽にし、病気を治すサポートをするためのものです。
では
病気を治すために、どこも痛くもなく元気なのに、副作用の大きな薬を飲む場合があります。
毒を毎日、半年、一年も飲み続けて、人間は生きてはいられません。
耐えきる人もいますが、普通は死んでしまいます。
薬は病気を一時的に止めるものであり、病気を治すために使うことは、薬の正しい使い方ではありません。
つらい思いだけして、最終的に死んでしまうから、医師は、副作用の大きな薬を飲まないのではないでしょうか。
さらに
病気は薬で治るのではなく、人間の身体が治す。
人間の身体には、健康な状態を保ち、健康な状態に戻そうとする力があります。


大きな病気になった時点で、あなたの身体は弱っている。
あなたの身体が、あなたを病気から守りきれなくなるほどに弱ってしまったから、病気になったと言えます。
弱っている身体をさらに薬で弱らせれば、病気が治りにくくなるのは必然。
つらい薬を飲めば飲むほど、病気が治せない身体になります。
何も手が施せなくなった時に、自分の身体の力で治そうと思っても、弱り切った身体ではもう病気は治せません。

身体が弱るもう一つの理由は、闘病のストレス。
薬の副作用で身体に起こる変化は、精神的に相当なストレス。
治るかどうかもわからない状況で、つらく苦しい状態に、半年、1年も耐えなければなりません。
心と身体はリンクしています。

病は気から。心が弱れば、身体も連動して弱ります。
身体と心の両方が弱ることで、さらに病気を治りにくくしています。
医師が、つらい薬を飲まないのは、病気を治すものではないから。
そして、病気を治せない身体になってしまうからではないでしょうか。
なぜなら
病気は薬で治すもの、自分では治せないものと考えているから。
くつがえすことのできない常識が、現在の状況を作り出しているのかもしれません。
しかし、昔はそうではありませんでした。
昔と言っても、まだ100年も経っていない話です。
病は医師が治すのではなく、身体が病を治す。
医学の父と言われる、ヒポクラテスが残した言葉です。大昔から、医師たちはこのように考えてきました。

ヒポクラテス
古代ギリシャの医師であるヒポクラテス(紀元前460年 – 紀元前370年)は、「医学の父」、「医聖」、「疫学の祖」などと呼ばれる人物です。
戦争の時に、人類の考え方は逆転してしまった。
1928年に、世界初の抗生物質であるペニシリンが発見されます。1942年に実用化され、第二次世界大戦中に多くの負傷兵や戦傷者を救ったことから、「20世紀における偉大な発見」 と言われています。
抗生物質 ペニシリン
それまでは死に至るしかなかった細菌性の感染症に劇的な効果を発揮しました。
これによって
これからは、すべての病気を、薬が治すと考えるようになった。
歴史的に見れば、まだ100年も経っていない考え方です。

しかし、そうではなかった。やはり、病気は人間の身体が治すもの。
間違っていた現在の常識を、もとの正しい常識に戻す時が来ています。
人間の身体には、病気を治そうとする力がある。
人間の自己修復機能
SCS
Self-Care System

人間の自己修復機能
SCS
Self-Care System
すべてを人間の身体にまかせたほうが、もっとうまくいく。
人間の手で身体をいじればいじるほど、問題は解決しにくくなります。
そもそも
人間の身体の機能のおかげで健康を維持できているのであり、その機能が弱れば、問題が生じるのは必然です。
問題の本質は、疲れ弱ってしまったあなたの身体と心にあります。

人間の自己修復機能は、健康的でない生活習慣、仕事や人間関係のストレスによって大きく低下します。
身体と心が元気になれば、自然と健康問題は解決の方向に向かうように人間の身体はできています。
病気を治す条件
運動・食事・睡眠の正しいサイクル
身体の自己修復機能を高めてくれます。
ストレスの発散
身体の自己修復機能の低下を防いでくれます。
必要なことは、特別なことではありません。
上記の2つが、あなたが病気を治すために、はじめに取り組まなければならないことです。
これからは
薬を使わずに自分の力で。

医師は、つらい薬を飲まない。